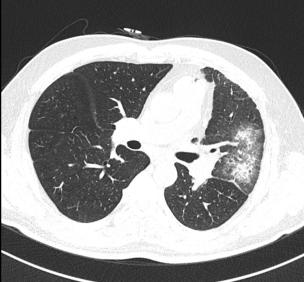

10.8*8.5mm、7.2*5.3mm的肺结节,是肺癌吗?| CACP 2020
原创 CACP报道小组 医学界呼吸频道

中国医师协会呼吸医师分会2020年会暨第十九届中国呼吸医师论坛(以下简称CACP 2020)选择以网络直播形式于7月24-26日召开。
在国内COVID-19已进入零星散发后半段,世界范围内仍在广泛流行的时刻,本次会议有着十分特殊而珍贵的意义:经验的总结与分享,教训的反思和未来学科发展和人才培养的展望也成为了本次大会的核心。
在大会的第一日,国家卫健委临床重点专科呼吸内科负责人白春学教授介绍了肺小结节的诊治现状,并以病例的形式分享他的临床经验。
精彩内容,一起来看!
01 肺结节诊治中有何问题?
首先,白教授提出了目前诊治工作中的一些问题,简单可以归纳为以下几点:
1、没有执行共识或指南造成过度治疗或延误诊断;
2、小结节诊断有难点,读片能力需要长期培养;
3、评估小结节内部结构是世界难题,专家阅片难以精准评估小结节内部结构。
综上,白教授提出了他的解决办法,运用人工智能方法,综合结节形态以及血管生成情况进行影像学分析。
02 发现双肺小结节1年,到底是不是癌?
患者,女,49岁,既往无吸烟史;CT发现双肺小结节1年,为进一步明确诊断进行薄层CT扫描并将影像学资料交与AI进行进一步判定。
AI判读发现患者右上肺有10.8*8.5 mm结节,且在左肺见7.2*5.3 mm结节。两结节均呈现空泡征且有新生血管生成,左肺结节更是存在分叶征。

最初发现右肺结节时,由于结节较小判读比较困难,医生并没有给出明确诊断而时嘱托患者继续随访。本次患者影像学经AI评估,认为患者右上肺结节可能高度恶性可疑,左下肺结节恶性风险稍低但依然存在。
由于患者存在双侧肺结节且恶性可能性大,尽管手术以及术后管理存在风险,但经过胸外科和呼吸内科MDT评估后,该患者接受同时的双侧肺结节切除。
术中病理提示:患者右肺结节为浸润性肺腺癌,左肺结节为微浸润性腺癌,术后病理与术中冰冻病理一致。
患者术后病例分期为Ia期,但考虑到患者存在双肺结节,复发可能性依然存在。于是患者进入了临床研究,接受了表观遗传学的检测。
结果显示患者复发可能性大,经充分沟通后家属同意加强术后管理(远离雾霾以及烟草污染),术后6月复查薄层CT并进行AI评估。目前患者恢复较好,无复发征象。
我们回顾这一病例可以发现,该患者两次影像学检查均处于相当早期,当没有太多经验的影像科医生或呼吸内科医生面对这一病例时,可能并不能确定结节的良恶性,而建议患者等待观察治疗。
这种等待却在无意间延误了患者的诊断和治疗,使得预后更差、预期寿命更短。而AI集合了经验丰富医生的宝贵临床见识并累加了他们的读图能力,做到了早期识别和确认,让患者得到了早期治疗。
03 物联网医学让诊断更加精准
全面感知,可靠传输以及智能处理三大基础流程是物联网所必须的要素,当物联网与医学相联系时可让患者获益更多。
物联网医学概念于2008年被提出,2014年被正式应用于临床。由于目前各医院和医生之间医学影像诊断和临床经验差别很大,使得早期肺癌延误诊断率较高,部分医院和医生对早期肺癌的过度治疗率较高。所以积极的推动物联网医学的发展具有重大的意义。
在病例分享中,我们对AI以及物联网医疗诊断肺(微小)结节已经有了初步的感知,也感受到在AI的辅助下,(微小)结节的诊断更是如虎添翼,不仅做到了更少漏诊,也做到了更高的特异性诊断。
“这既有利于广泛筛查无症状的肺结节患者、对早期肺癌及时进行管理,也有利于多学科会诊和随访跟踪。”白教授最后总结谈到。
专家简介

上海市呼吸病研究所所长,复旦大学呼吸病研究所所长,亚太呼吸学会科学委员会主席,中国肺癌防治联盟主席,中华医学会呼吸分会肺癌学组顾问,中国医师协会呼吸分会副会长兼首届肺癌工作委员会主委,中国非公医疗机构协会物联网医学分会主席。
Clinical eHealth主编,SCI索引杂志:《IJ COPD》 和《J Proteomics》副主编,《Cancer》杂志中国首位编委,美国《美国呼吸危重医学杂志》、《呼吸细胞分子生物学杂志》和《胸》杂志犏委。
本文首发:医学界呼吸频道
本文报道:锦鲤
原标题:《10.8*8.5mm、7.2*5.3mm的肺结节,是肺癌吗?| CACP 2020》

